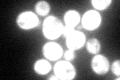
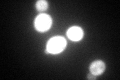
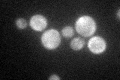

View description
Cytoplasmic and mitochondrial histidine tRNA synthetase; encoded by a single nuclear gene that specifies two messages; efficient mitochondrial localization requires both a presequence and an amino-terminal sequence
Localization:
Intensity:
Fold change:
Significance:
-
C’ GFP library in SD
cytosol143.22 -
N' NOP1pr-GFP in SD

mitochondria111.046 -
N' TEF2pr-mCherry in SD

missing0 -
N' NATIVEpr-GFP in SD

missing0 -
N' TEF2pr-VC and Cyto-VN in SD

#N/A0 -
C’ GFP library in SD+DTT
cytosol127.280.88No -
C’ GFP library in SD+H2O2

cytosol158.581.1No -
C’ GFP library in Starvation Media
cytosol82.480.57Yes -
C’ GFP library on the background of Pup2-DaMP

cytosol -
C’ GFP library on the background of CCT mutant

cytosol149.2481.04197No
